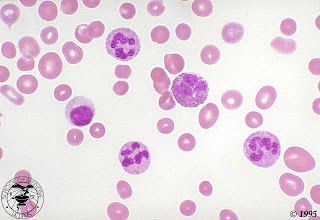

Megaloblastik anemiler vitamin B12 ve/veya folik asit eksikliği sonucu gelişir. Her ikisi de nükleoprotein sentezinde kofaktör olarak rol alırlar. Eksikliklerinde DNA ve bir ölçüde de RNA’nın sentezi bozulur. Gelişimi duraklayan hücrelerin kemik iliğinde erken ölümü sonucu ineffektif eritropoezis ortaya çıkar.
Periferik yaymada eritrositler makrositer ve hafif ovaldir. Nötrofillerin segment sayısı artmıştır. Dev trombositler görülebilir. Ağır vakalara pansitopeni eşlik edebilir.
Folik Asit Eksikliği ;
Folik asit kaynağı: Folik asit yeşil sebzeler (ıspanak), meyveler (portakal) ve karaciğer-böbrekde fazlaca bulunur. Ancak günlük ihtiyacın 1/3’ü tahıllardan, 1/3’ü sebze ve meyvelerden ve diğer 1/3’ü et ve balıktan sağlanır. İnce bağırsak boyunca emilir. Enterohepatik sirkülasyonu vardır. Anne sütü ve inek sütünde yeterli miktarda vardır. Ancak keçi sütü hemen hemen hiç folik asit içermez. İnek sütünün uzun kaynatılması sonucu folik asit düzeyi azalır.
Günlük gereksinim bebeklerde 3.6 µgr/kg, daha sonraki yaşlarda 3.3 µgr/kg kadardır.
Folik asit eksikliğinin gelişme sebebleri:
-
Yetersiz alım:
-
Prematüre ve düşük doğum ağırlıklı bebeklerde hızlı büyüme nedeni ile ihtiyaçları daha fazladır.
-
Hemolitik hastalığı olan çocuklarda hızlı eritropoez nedeni ile ihtiyaç artmıştır.
-
Malnütrisyon çoğu kez mikrobesin yetersizlikleri ile birlikte olur.
-
Yiyeceklerin aşırı pişirilmesi
-
-
Emilim yetersizliği:
-
Malabsorpsiyon sendromları
-
İnce bağırsak rezeksiyonları
-
Konjenital folat malabsorpsiyonu:
-
-
İlaçlara Bağlı: Antikonvülzan (difenil hidantoin, fenobarbital) ilaçlar, methotrexate, pyrimathamine, trimethoprim kullanımı sırasında folik asit eksikliği ortaya çıkabilir.

2. Tedavi?
-
Beslenmenin düzeltilmesi
-
Folik asit desteği: 0.2-0.5 mg/gün folik asit ile folik asit eksikliğine bağlı megaloblastik anemi tedavi edilebilir. Vit B12 eksikliklerinde folik asit kullanıldığında nörolojik yan etkileri artırdığı bilinmektedir. Ancak 0.2-0.5 mg/gün kadar dozlar Vit B12 eksikliğinde hematolojik düzelme sağlamaz. Ancak folik asit tabletleri 5 mg’lık olduğundan yüksek dozlar kullanılacak ise mutlaka vit B12 düzeyi bilinmelidir. Vit B12 eksikliğinin olmadığı gösterildiği takdirde yüksek doz folik asitin kullanılmasında bir sakınca yoktur.